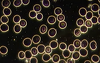
Bild 3

AUKTIONSENDE IN
Dunkelfeld Vitalblutanalyse und HRV Messung
STECKBRIEF
Wichtige Info zu Ihrem Kauf
Bei der Krone Online Auktion kaufen Sie beim jeweiligen Anbieter/Händler ein, die Auktion ist nur eine Plattform. Daher kommt Ihr Kaufvertrag im Falle eines Zuschlags mit dem Anbieter zustande und nicht mit der Kronen Zeitung. Der Anbieter ist für die Erfüllung des Vertrags verantwortlich und ist Ihr direkter Ansprechpartner bei Fragen zur Leistung oder bei Problemen. Siehe dazu auch Punkt 6 unserer Allgemeinen Auktionsbedingungen: https://auktion.krone.at/aabProduktbeschreibung
Dunkelfeld Vitalblutanalyse, was ist das?
Zur Untersuchung des Blutes wird nur ein Tropfen Blut benötigt.
Dieser wird aus aus der Fingerbeere entnommen.
Dieser Blutstropfen wird am Objektträger im Dunkelfeldmikroskop unter verschiedenen Vergrößerungen untersucht. Von 100-facher über
400-facher bis 1000-facher Vergrößerung wird die Zusammensetzung des Blutes bestimmt.
Mikroorganismen, Kristalle, parasitäre Belastungen, Spirochäten (Borrelien), Würmer, Filite, E-Smog, oxidativer Stress, Impfschäden und einiges mehr, können festgestellt werden.
Eines der Ziele der Diagnose ist es, die verschiedenen Mikroorganismen im Blut zu identifizieren, um den Zustand einzelner Organe, Organsysteme und Körperregionen zu erkennen. Dadurch ist es oft möglich, Krankheiten zu erkennen, lange bevor diese ausbrechen und Beschwerden verursachen.
Da der Zustand der Blutgefäße von besonderer Bedeutung ist, wird eine Herz -Raten-Variabilitäts (HRV) und eine Stress-Belastungs Messung durchgeführt.
Für mehr Informationen siehe auf der Webseite www.gnhz.at
Aus rechtlichen Gründen sei gesagt, wir erstellen naturheilkundliche Diagnosen, für eine medizinische Diagnose ist ausschließlich der Arzt autorisiert.
Anbieter
8605 Kapfenberg